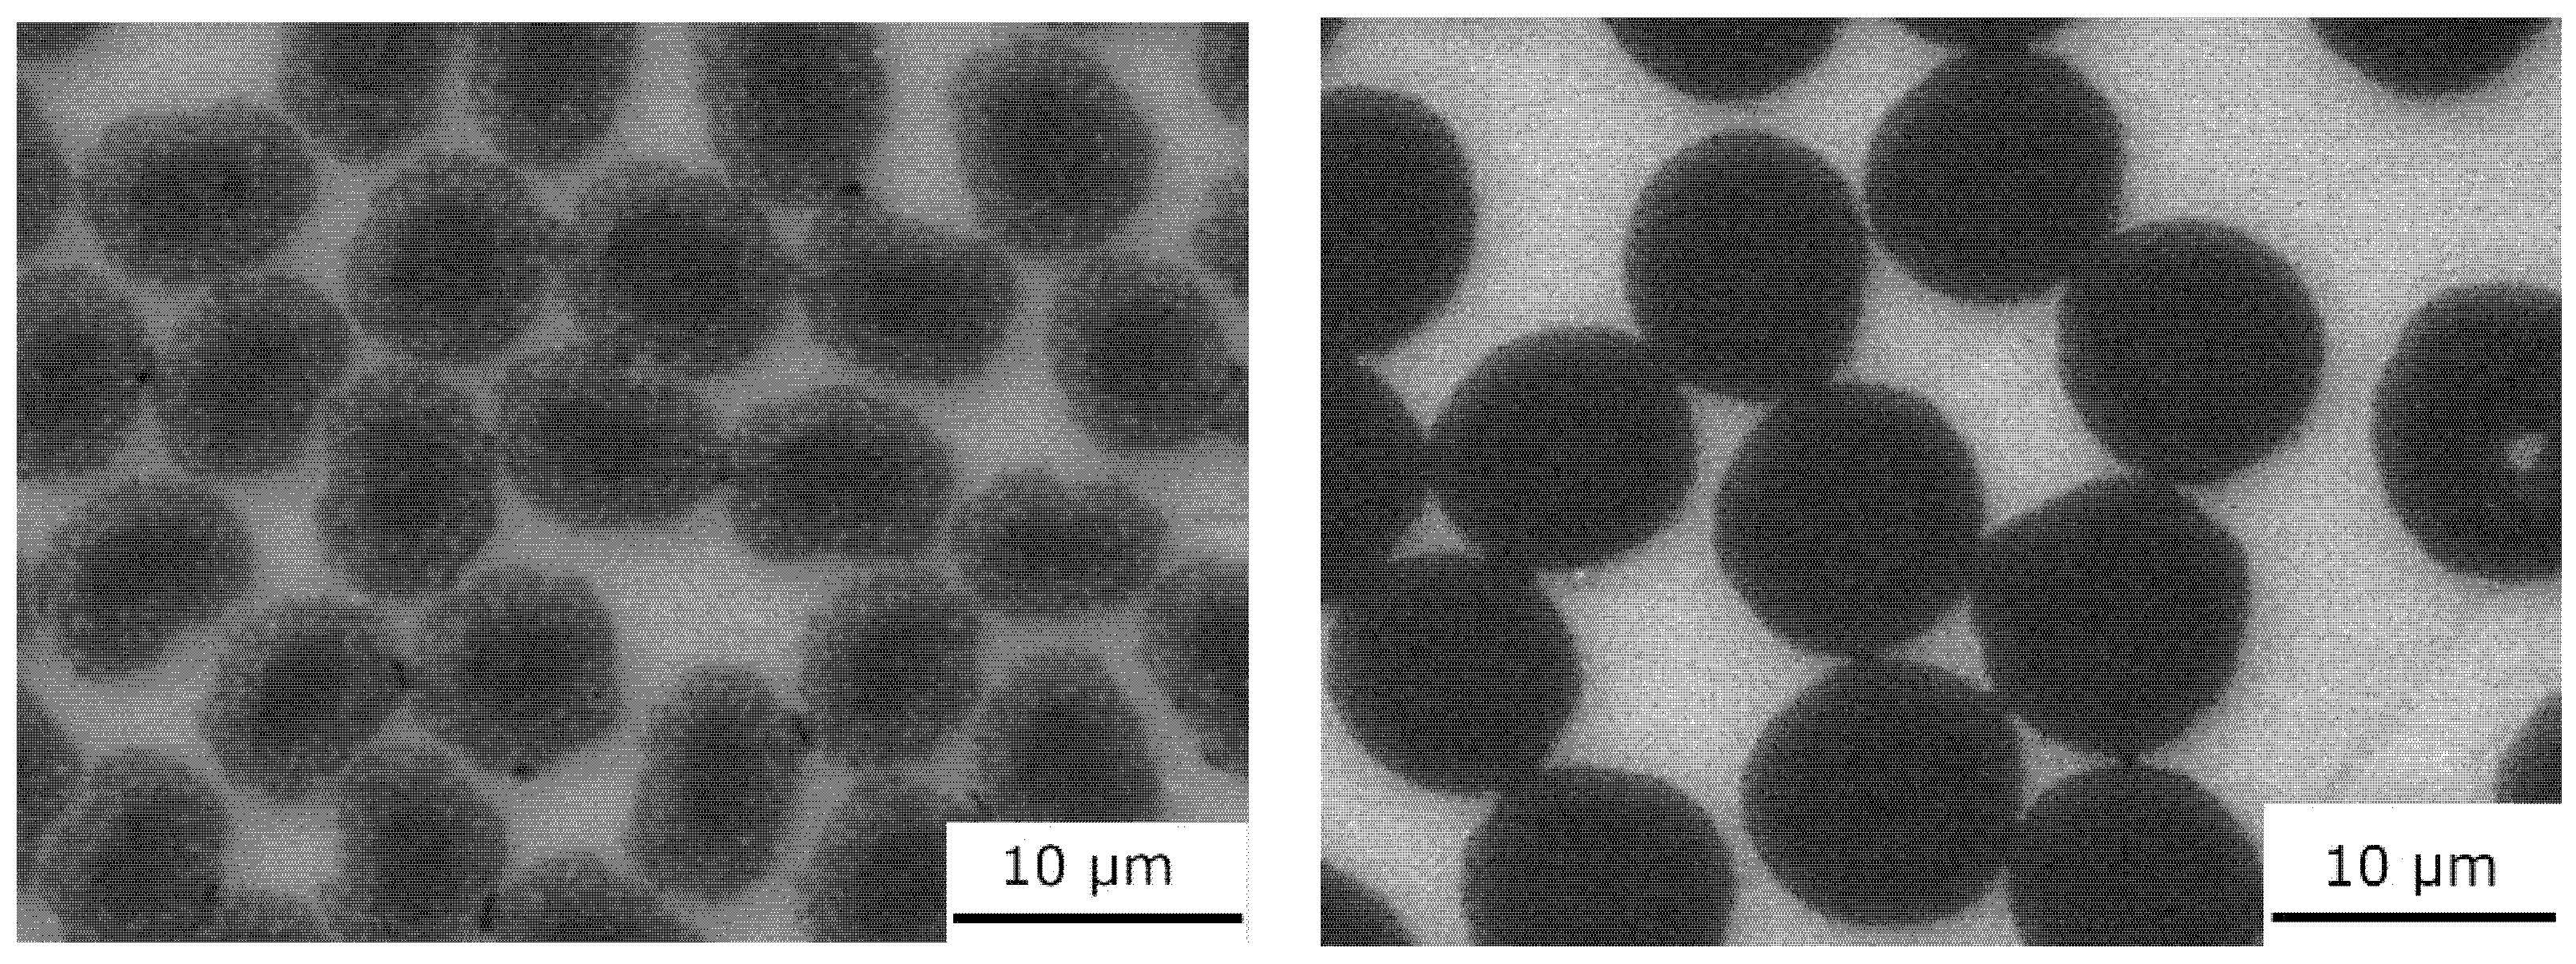
Materials 15 07812 g010

Effect of Temperature on the Complex Modulus of Mg-Based Unidirectionally Aligned Carbon Fiber Composites
Abstract
1. Introduction
2. Materials and Methods
2.1. Magnesium Alloy Preparation
2.2. Carbon Fibers (T300, Granoc)
2.3. Gas Pressure Infiltration Method
2.4. Dynamic Mechanical Testing
2.5. SEM and TEM Observations and EDX Analysis
3. Results and Discussion
3.1. Composite Structure
3.1.1. Structure of Mg1.8Y/CF Composites
3.1.2. Structure of the Mg2Li/CF Composites
3.1.3. Composite Structure after the DMA Measurements
3.2. Dynamic Mechanical Properties
3.2.1. Complex Modulus of Magnesium
3.2.2. Complex Moduli of Mg-Based CF Composites
3.2.3. Damping capacity of the Mg-Based CF composites
3.3. Interfacial Bond Transfer Efficiency
4. Conclusions
- (1)
- Two types of interfacial bonding were presented, reaction bonding with the reaction product in the interfacial area (Mg1.8Y/CF) and reaction bonding without the reaction product in the interfacial area (Mg2Li/CF);
- (2)
- The complex modulus values slightly increased in the temperature range of 50–250 °C in both types of Granoc fiber composites, while in both types of T300 fiber composites the complex modulus values remained constant over the temperature range introduced here;
- (3)
- The highest complex modulus in the group of Granoc fiber composites was for the Mg2Li matrix composites over the temperature range introduced here;
- (4)
- In the group of T300 fiber composites, the highest complex modulus was for the Mg1.8Y matrix composites over the temperature range introduced here;
- (5)
- Both magnesium matrices (Mg1.8Y, Mg2Li) showed better bonding efficiency in the T300 fiber composites compared to the Granoc fiber composites. This can be related to the ridge-like geometry of the T300 carbon fibers, the higher content of nitrogen in the T300 carbon fibers, and the different degrees of ordering in the internal structures of the T300 and Granoc fibers;
- (6)
- D = The damping capacity is related to the quality of the interfacial bonding, whereby lower-quality interfacial bonding results in a higher damping capacity.
Author Contributions
Funding
Institutional Review Board Statement
Informed Consent Statement
Data Availability Statement
Acknowledgments
Conflicts of Interest
References
- Liu, W.; Zhou, B.; Wu, G.; Zhang, L.; Peng, X.; Cao, L. High temperature mechanical behavior of low-pressure sand-cast Mg–Gd–Y–Zr magnesium alloy. J. Magnes. Alloy 2019, 7, 597–604. [Google Scholar] [CrossRef]
- Kulekci, M.K. Magnesium and its alloys applications in automotive industry. Int. J. Adv. Manuf. Technol. 2008, 39, 851–865. [Google Scholar] [CrossRef]
- Tan, J.; Ramakrishna, S. Applications of Magnesium and Its Alloys: A Review. Appl. Sci. 2021, 11, 6861–6877. [Google Scholar] [CrossRef]
- Luo, A.A. Magnesium casting technology for structural applications. J. Magnes. Alloys 2013, 1, 2–22. [Google Scholar] [CrossRef]
- Shi, H.; Xu, C.H.; Hu, X.; Gan, W.; Wu, K.; Wang, X. Improving the Young’s modulus of Mg via alloying and compositing—A short review. J. Magnes. Alloys 2022, 10, 2009–2024. [Google Scholar] [CrossRef]
- Zhou, X.; Su, D.; Wu, C.; Liu, L. Tensile Mechanical Properties and Strengthening Mechanism of Hybrid Carbon Nanotube and Silicon Carbide Nanoparticle-Reinforced Magnesium Alloy Composites. J. Nanomaterials 2012, 851862, 7. [Google Scholar] [CrossRef]
- Upadhyay, G.; Saxena, K.K.; Sehgal, S.; Mohammed, K.A.; Prakash, C.H.; Dixit, S.; Buddhi, D. Development of Carbon Nanotube (CNT)-Reinforced Mg Alloys: Fabrication Routes and Mechanical Properties. Metals 2022, 12, 1392. [Google Scholar] [CrossRef]
- Guan, H.; Xiao, H.; Ouyang, S.; Tang, A.; Chen, X.; Tan, J.; Feng, B.; She, J.; Zheng, K.; Pan, F. A review of the design, processes, and properties of Mg-based composites. Nanotechnol. Rev. 2022, 11, 712–730. [Google Scholar] [CrossRef]
- Dey, A.; Pandey, K.M. Magnesium metal matrix composites—A review. Rev. Adv. Mater. Sci. 2015, 42, 58–67. [Google Scholar]
- Trojanová, Z.; Drozd, Z.; Lukáč, P.; Džugan, J. Studying the Thermally Activated Processes Operating during Deformation of hcp and bcc Mg–Li Metal-Matrix Composites. Metals 2021, 11, 473. [Google Scholar] [CrossRef]
- Sun, Y.; Wang, R.; Peng, C.; Feng, Y.; Yang, M. Recent progress in Mg−Li matrix composites. Trans. Nonferrous Met. Soc. China 2019, 29, 1–14. [Google Scholar] [CrossRef]
- Newcomb, B.A. Processing, structure, and properties of carbon fibers. Compos. Part A Appl. Sci. Manuf. 2016, 91, 262–282. [Google Scholar] [CrossRef]
- Körner, C.; Schäff, W.; Ottmüller, M.; Singer, R.F. Carbon long fiber reinforced magnesium alloys. Adv. Eng. Mater. 2000, 2, 327–337. [Google Scholar] [CrossRef]
- Ye, H.Z.; Liu, X.Y. Review of recent studies in magnesium matrix composites. J. Mater. Sci. 2004, 39, 6153–6171. [Google Scholar] [CrossRef]
- Kudela, S.; Gergely, V.; Jänsch, E.; Hofmann, A.; Baunack, S.; Oswald, S.; Wetzig, K. Compatibility between PAN-based carbon fibres and Mg8Li alloy during the pressure infiltration process. J. Mater. Sci. 1994, 29, 5576–5582. [Google Scholar] [CrossRef]
- Kúdela, S., Jr.; Bajana, O.; Orovčík, Ľ.; Ranachowski, P.; Ranachowski, Z. Strengthening in MgLi matrix composites reinforced with unidirectional T300 and Granoc carbon fibres. Kovove Mater. 2020, 58, 223–231. [Google Scholar]
- Goertzen, W.K.; Kessler, M.R. Dynamic mechanical analysis of carbon/epoxy composites for structural pipeline repair. Composites B 2007, 38, 1–9. [Google Scholar] [CrossRef]
- Luz, F.S.; Monteiro, S.N.; Tommasini, F.J. Evaluation of Dynamic Mechanical Properties of PALF and Coir Fiber Reinforcing Epoxy Composites. Mater. Res. 2018, 21, e20171108. [Google Scholar] [CrossRef]
- Patra, S.; Ajayan, P.M.; Narayanan, T.N. Dynamic mechanical analysis in materials science: The Novice’s Tale. Oxf. Open Mater. Sci. 2021, 1, itaa001. [Google Scholar] [CrossRef]
- Yu, S.R.; Li, F.G.; Chu, H.C.; Liu, E.Y. The influence of FAC particle size on the damping capacity and dynamic Young’s modulus of AZ91D/FAC composites at high temperature. Int. J. Mater. Res. 2018, 109, 539–544. [Google Scholar] [CrossRef]
- Madeira, S.; Carvalho, O.; Carneiro, V.H.; Soares, D.; Silva, F.S.; Miranda, G. Damping capacity and dynamic modulus of hot pressed AlSi composites reinforced with different SiC particle sized. Compos. Part B. Eng. 2016, 90, 399–405. [Google Scholar] [CrossRef]
- Acar, E.; Aydın, M. Damping behavior of Al/SiC functionally graded and metal matrix composites. J. Asian Ceram. Soc. 2021, 9, 578–585. [Google Scholar] [CrossRef]
- Kúdela, S., Jr.; Bajana, O.; Orovčík, Ľ.; Ranachowski, P.; Ranachowski, Z. Alloying effect of Li and Y on the strengthening of Mg/T300 composites. Kovove Mater. 2020, 58, 151–159. [Google Scholar]
- Torayca Data Sheet, Tokio; Toray Industries Inc., Toray Industries: Tokyo, Japan, 2011.
- Granoc Yarn XN Series, Nippon Graphite Fiber Corporation. Available online: www.ngfworld.com (accessed on 8 September 2022).
- Qin, X.; Lu, Y.; Xiao, H.; Wen, Y.; Yu, T. A comparison of the effect of graphitization on microstructures and properties of polyacrylonitrile and mesophase pitch-based carbon fibers. Carbon 2012, 50, 4459–4469. [Google Scholar] [CrossRef]
- Hufenbach, W.; Andrich, M.; Langkamp, A.A. Czulak. Fabrication technology and material characterization of carbon fibre reinforced magnesium. J. Mater. Process. Technol. 2006, 175, 218–224. [Google Scholar] [CrossRef]
- Zhang, S.; Chen, G.; Pei, R.; Li, D.; Wang, P.; Wu, G. Effect of Y addition on the interfacial microstructures and mechanical properties of Cf/Mg. Mater. Sci. Eng. A Struct. Mater. 2014, 613, 111–116. [Google Scholar] [CrossRef]
- Zhang, S.; Chen, G.; Pei, R.; Wang, Y.; Li, D.; Wang, P.; Wu, G. Effect of Y content on interfacial microstructures and mechanical properties of Cf/Mg composite. Mater. Sci. Eng. A Struct. Mater. 2015, 647, 105–112. [Google Scholar] [CrossRef]
- Yu, W.; Li, X.; Vallet, M.; Tian, L. High temperature damping behavior and dynamic Young’s modulus of magnesium matrix composite reinforced by Ti2AlC MAX phase particles. Mech. Mater. 2019, 29, 246–253. [Google Scholar] [CrossRef]
- Kang, C.S.; Maeda, K.; Wang, K.J.; Wakashima, K. Dynamic Young’s modulus and internal friction in particulate SiC/Al composites. Acta Mater. 1998, 46, 1209–1220. [Google Scholar] [CrossRef]
- Munitz, A.; Dayan, D.; Pitchure, D.; Ricker, R. Dynamic mechanical analysis of pure Mg and Mg AZ31 alloy. In Magnesium Technology 2004 (The Minerals, Metals & Materials Society); Alan, A., Luo, T.M.S., Eds.; TMS: Charlotte, NC, USA, 2004. [Google Scholar]
- Chang, T.C.; Wang, J.Y.; Chu, C.L.; Lee, S. Mechanical properties and microstructures of various Mg-Li alloys. Mater. Lett. 2006, 60, 3272–3276. [Google Scholar] [CrossRef]
- Available online: https://www.jinjiuyi.net/news/difference-between-t300-t700-and-t800-carbon-fiber.html (accessed on 29 July 2020).
- Chand, S. Review Carbon fibers for composites. J. Mater. Sci. 2000, 35, 1303–1313. [Google Scholar] [CrossRef]
- Edie, D.D. The effect of processing on the structure and the properties of carbon fibers. Carbon 1998, 36, 345–362. [Google Scholar] [CrossRef]
- Chung, D.D.L. Review Graphite. J. Mater. Sci. 2002, 37, 1475–1489. [Google Scholar] [CrossRef]

| Carbon Fibre | Producer | Fiber Type | E-Modulus [GPa] | Tensile Strength [GPa] | Density [g cm−3] | Diameter [µm] | CTE [10−6 K−1] |
|---|---|---|---|---|---|---|---|
| Torayca T-300 | Toray | PAN | 230 | 3.53 | 1.76 | 7 | −0.41 |
| Granoc XN90-60S | Nippon Graphite Fibre Corporation | PITCH | 860 | 3.50 | 2.20 | 10 | −1.5 |
| Sample | E(ROM) Modulus [GPa] | E/E(ROM) | E modulus (50 °C) [GPa] | E modulus (150 °C) [GPa] | E modulus (250 °C) [GPa] |
|---|---|---|---|---|---|
| Mg1.8Y/T300 | 132.5 | 1.03 | 136.3 | 137.1 | 136.7 |
| Mg2Li/T300 | 132.5 | 0.89 | 118.9 | 120.7 | 118.1 |
| Mg1.8Y/Granoc | 447.5 | 0.44 | 198.7 | 208.6 | 211.3 |
| Mg2Li/Granoc | 447.5 | 0.49 | 219.1 | 225.5 | 235.9 |
| Sample | Estorage (50 °C) [GPa] | Eloss (50 °C) [GPa] | Estorage (150 °C) [GPa] | Eloss (150 °C) [GPa] | Estorage (250 °C) [GPa] | Eloss (250 °C) [GPa] |
|---|---|---|---|---|---|---|
| Mg | 34.9 | 1.6 | 33.6 | 1.4 | 30.9 | 2.2 |
| Mg1.8Y/T300 | 136.3 | 1.3 | 137.1 | 1.4 | 136.6 | 1.4 |
| Mg2Li/T300 | 118.9 | 1.4 | 120.7 | 1.3 | 118.1 | 1.2 |
| Mg1.8Y/Granoc | 198.5 | 8.1 | 208.5 | 7.7 | 211.2 | 7.0 |
| Mg2Li/Granoc | 219.1 | 4.7 | 225.5 | 3.4 | 235.9 | 3.1 |
Publisher’s Note: MDPI stays neutral with regard to jurisdictional claims in published maps and institutional affiliations. |
© 2022 by the authors. Licensee MDPI, Basel, Switzerland. This article is an open access article distributed under the terms and conditions of the Creative Commons Attribution (CC BY) license (https://creativecommons.org/licenses/by/4.0/).
Share and Cite
Kúdela, S., Jr.; Koráb, J.; Štefánik, P. Effect of Temperature on the Complex Modulus of Mg-Based Unidirectionally Aligned Carbon Fiber Composites. Materials 2022, 15, 7812. https://doi.org/10.3390/ma15217812
Kúdela S Jr., Koráb J, Štefánik P. Effect of Temperature on the Complex Modulus of Mg-Based Unidirectionally Aligned Carbon Fiber Composites. Materials. 2022; 15(21):7812. https://doi.org/10.3390/ma15217812
Chicago/Turabian StyleKúdela, Stanislav, Jr., Juraj Koráb, and Pavol Štefánik. 2022. "Effect of Temperature on the Complex Modulus of Mg-Based Unidirectionally Aligned Carbon Fiber Composites" Materials 15, no. 21: 7812. https://doi.org/10.3390/ma15217812
APA StyleKúdela, S., Jr., Koráb, J., & Štefánik, P. (2022). Effect of Temperature on the Complex Modulus of Mg-Based Unidirectionally Aligned Carbon Fiber Composites. Materials, 15(21), 7812. https://doi.org/10.3390/ma15217812

